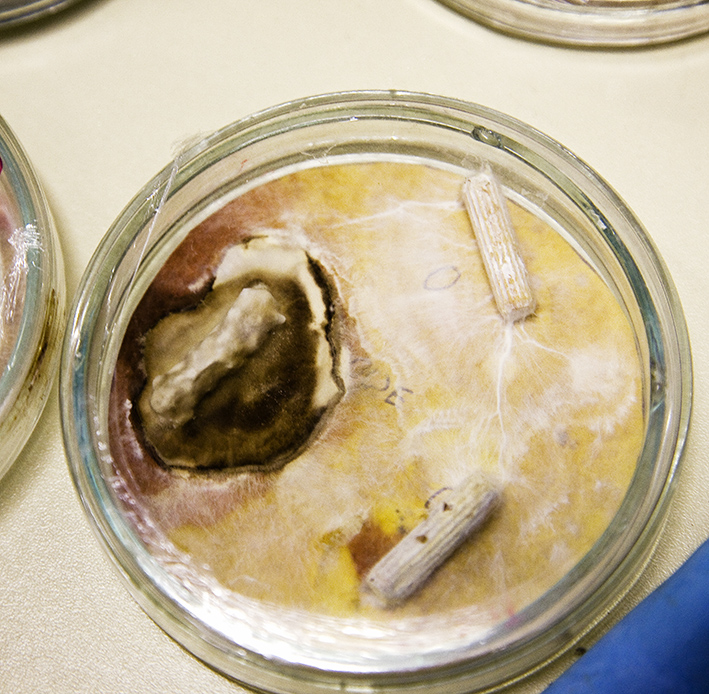

|
|
Nomadology (Rhizome Nomad), 2012 |
Concept: Polona Tratnik (leader), micology: Andrej Gregori, Mirjan Švagelj, Ajda Marič, Marin Berovič, photography: Damjan Švarc, film: Marko Cafnik.
Producer: Horizonti; collaborating organizations: Institute for Natural Sciences Ljubljana (Andrej Gregori, PhD and Marija Gregori, PhD), Faculty of Chemistry and Chemical Technology (Prof. Marin Berovič, PhD, Mirjan Švagelj, PhD), Snaut (Marko Cafnik).
The project is conceptualized around the central issues of contemporary society and biology as knowledge and technology, which characterize the present time and society from several aspects. In 1980 Gilles Deleuze and Felix Guattari defined the concept of the rhizome as the basic model for the existence of contemporary society. As a starting point they took the biological model of the rhizome, which they recognized in the mycelium, multiplication of orchids in relation to wasps, bulbs and mice tunnels. The basic aim in introducing this concept was to oppose the modern thought consolidated by G. W. F. Hegel, which was grounded in the model of a tree. This model, which thus also has a biological origin, establishes a centralised organization, genealogy, which is founded on the ideas of origin, goal and development. On such grounds, Hegel understood world history, which progressively spirally as a totality develops towards its telos, the internal sense, origin and goal, but within which one can track a constant appearance of beginnings and endings (as the dying of particular organisms that takes place and the continuity of the evolution of the species). As post-structuralists, Deleuze and Guattari aim to turn away from Hegel in their work, and instead of development and progression, originate from the idea of structure. But with the concept of the rhizome they even try to exceed the notion of the underlying structure (as it was considered in structuralism), which would, by acting like a genotype, define the phenotype and would thus represent the internal essence, which defines any particular formation in spatialisation. The rhizome is on the contrary already the world itself, it does not exist as representation, a tracing of the world (as for example photography), which would stop the world and paralyze it. The rhizome is the becoming, is a process, its being is constituted from lines and not positions. Thus the authors propose nomadology instead of (the science of) history, as nomadology is the essence of the rhizome. In 2000 Antonio Negri and Michael Hardt condensed their reflections on contemporary society, power and resistance in the concept of the Empire, which presents the social consolidation of power on a global scale. The Empire is structured as a rhizome, in which the crucial process is contemporary nomadism (multitudes of people, but also as migration and deterritorialization of power; the contemporary tactics of resistance must also organize themselves in a nomadic way). At the end of the 1960s the American Defense Advanced Research Project Agency supported the development of the information network, which entered the commercial sphere in the 1980s and 1990s, and then became the crucial date-communication system. The internet is a technological model of a rhizome, whereas today we can question its basic non-hierarchical structure or democracy also in the sense of the inclusion of recipients as equal transmitters. The tendency to interdisciplinarity or transdisciplinarity has also been explained as constructing a rhizome, where the disciplines separated in modernity as art, natural sciences and philosophy, are being connected and intertwined. The model of the rhizome is today recognized as the fundamental model of contemporary organization of society, yet it would be useful to reconsider it in its basic premises such as the requests for non-hierarchy, decentralization, heterogeneity (connecting and intertwining of diversity) as well as non-destructibility.
The aim of the project is to establish a rhizome on a literal level (as the literalness was actually also requested by Deleuze and Guattari). In such a manner we will establish a living biological system of a philosophical concept and thus perform a contrary trajectory as was done by Hegel, but also Deleuze and Guattari. The challenge of the project is recognized in the aesthetic (aesthesis in the sense: sensual) salvation of the problem, which is at the same time the biological method: the living rhizome and at the same time knowledge and technology, which establish it. Namely, we believe that we can only expect to get informative answers to complex issues, which might have experienced certain hindrances and transpositions that could represent changes of meaning in the sphere of pure reflection, in such a manner as to observe the life of the rhizomatic organism-system.
As researchers we are investigating the life of fungi and are observing the evolution of a rhizome, in which we carefully control the suitability of the in vitro conditions (sterility, humidity, etc.) and communicate with the fungi (direct them and consider their needs) through a delivery of nutritive and non-nutritive, and even toxic, substances. The potentials of the fungi for communication, their sensual systems and systems of survival have not yet been explored. However, present research indicates that fungi detect the location of nourishing substances to which they are directed by the mycelium, and conversely, they sense the presence of inedible substances, which the mycelium then systematically avoids. The established rhizome nourishes itself with some substances that man understands as uneatable or even poisonous. In such a manner the project thematizes also contemporary ecosystem and is thus informative from the ecological perspective, preservation and cleansing of environment or sustainable environmental development, for the investigation of healing effects and the role of fungi in food industry, as well as within the broader chain of survival. |
|
Nomadologija (Rizom nomad), 2012 (prva predstavitev za Kiparstvo danes, Galerija sodobnih umetnosti Celje)
Produkcija: Horizonti; sodelujoče organizacije: Zavod za naravoslovje, Ljubljana (dr. Andrej Gregori in dr. Marija Gregori), Fakulteta za kemijo in kemijsko tehnologijo (prof. dr. Marin Berovič, dr. Mirjan Švagelj), Snaut (Marko Cafnik).
Koncept: Polona Tratnik (vodja), mikologija: Andrej Gregori, Mirjan Švagelj, Ajda Marič, Marin Berovič, fotografija: Damjan Švarc, film: Marko Cafnik.
Projekt Rizom nomad je zasnovan okoli nekaterih osrednjih vprašanj sodobne družbe in biologije kot vede in tehnologije, ki s številnih aspektov zaznamuje današnji čas in družbo.
Leta 1980 sta Gilles Deleuze in Felix Guattari opredelila koncept rizoma kot temeljnega modela za obstoj sodobne družbe. Pri tem sta izhajala iz biološkega modela rizoma, ki sta ga prepoznala v podgobju, razmnoževanju orhidej v povezavi z osami, gomoljih in mišjih rovih. Osnovni namen vpeljave tega koncepta je bilo nasprotovanje moderni misli, ki jo je še zlasti konsolidiral G. W. F. Hegel in ki je temeljila na modelu drevesa. Ta model, ki ima torej prav tako biološki izvor, utemeljuje centralizirano organizacijo, genealogijo, ki je izvorno utemeljena in ciljno-razvojno usmerjena. Na takšni osnovi je Hegel mislil svetovno zgodovino, ki se napredujoče spiralno kot totaliteta razvija k telosu, notranjemu smislu, izvoru in cilju, a znotraj katere se dogajajo pričetki in konci (kot vsakokratno umiranje posamičnih organizmov in kontinuiteta evolucije vrste). Deleuze in Guattari kot pripadnika poststrukturalistične misli si v svojem delu prizadevata obrniti krmilo proč od Hegla in namesto iz razvoja in napredovanja izhajata iz ideje strukture. Vendar s konceptom rizoma poskušata preseči tudi mišljenje spodaj ležeče strukture (kot jo misli strukturalizem), ki bi kot genotip določala fenotip in bi torej pomenila notranje bistvo, ki določa vsakršno partikularno uprostorjanje. Rizom je nasprotno že svet sam, ne obstaja kot reprezentacija, posnetek sveta, ni kalk (kot je npr. fotografija), ki ustavi svet in ga paralizira. Rizom je postajanje, je proces, konstituirajo ga linije in ne pozicije. Zato avtorja namesto zgodovinopisja predlagata nomadologijo, saj je nomadstvo bistvo rizoma. Leta 2000 Antonio Negri in Michael Hardt svoja razmišljanja o sodobni družbi, moči in odporu strneta v konceptu Imperija, ki predstavlja sodobno konsolidacijo oblasti na globalnem nivoju. Imperij je strukturiran kot rizom, v katerem je poglavitni proces sodobno nomadstvo (mnoštva ljudi, pa kot selitev in deteritorializacija moči; prav tako se morajo taktike odporništva organizirati nomadsko). Konec šestdesetih letih ameriško obrambno ministrstvo podpre razvoj podatkovnega omrežja, ki se v osemdesetih in devetdesetih letih prične uporabljati tudi v komercialne namene ter postane danes ključni podatkovno-komunikacijski sistem. Internet je tehnološki model rizoma, pri katerem danes lahko preizprašujemo njegovo osnovno nehierarhično osnovanost oziroma demokratičnost tudi v smislu vključitve sprejemnikov na načine enakovrednih oddajnikov. Rizomatsko se prav tako razlaga sodobno težnjo k interdisciplinarnosti in transdisciplinarnosti, prek katere se povezujejo in prepletajo v modernosti nezdružljiva področja, kot sta umetnost in znanost, naravoslovna znanost in filozofija itd. Model rizoma se danes kaže kot temeljni model sodobne družbene organizacije, pa vendar ga gre premisliti v njegovih temeljnih premisah, kot so zahteve po nehierarhičnosti, decentralizaciji, heterogenosti (povezovanju in prepletanju različnosti) in tudi neuničljivosti.
Namen projekta je vzpostavitev rizoma na dobesedni ravni (kot sta ne nazadnje ne-posredovanost zahtevala že Deleuze in Guattari), s čimer bomo v območju umetnosti vzpostavili živ biološki sistem filozofskega koncepta ter tako izvedli obratno pot, kot jo izvedejo Hegel pa tudi Deleuze in Guattari. Izziv projekta vidimo v estetskem (aesthesis, v smislu: na čuten način) reševanju problema, ki je obenem biološki način: živeč rizom in obenem vednost ter tehnologija, ki ga vzpostavljata. Namreč, verjamemo, da lahko le na ta način, prek opazovanja življenja rizomatskega organizma-sistema, pričakujemo informativne odgovore na zapletena vprašanja, ki so morda v območju čiste refleksije naletela na določene omejitve ali premestitve, ki lahko pomenijo premene smisla.
V projektu raziskujemo življenje gliv in opazujemo evolucijo rizoma, pri katerem skrbno nadzorujemo ustreznost in vitro okoliščin (sterilnost, vlažnost idr.) ter z glivami komuniciramo (jih usmerjamo in upoštevamo njihove potrebe) prek dovajanja hranljivih, nehranljivih in celo toksičnih snovi. Še neraziskani so potenciali gliv za komunikacijo, njihovi zaznavni sistemi in sistemi preživetja. A sodobne raziskave kažejo, da glive zaznajo lokacijo hranil in se micelij usmeri neposredno na njih, kot tudi zaznajo prisotnost neužitnih snovi, ki se jim micelij sistematično izogne. Vzpostavljeni rizom se prehranjuje tudi z nekaterimi snovmi, ki jih človek razume kot neužitne ali celo strupene, s čimer projekt v pomembnem segmentu tematizira sodobni ekosistem ter je tako informativen tudi s stališča ekologije, varstva oziroma čiščenja okolja ter okoljski trajnostni razvoj, za vprašanja zdravilnih potencialov in vloge gliv v prehrambni industriji ter širši preživetveni verigi. |
|
|